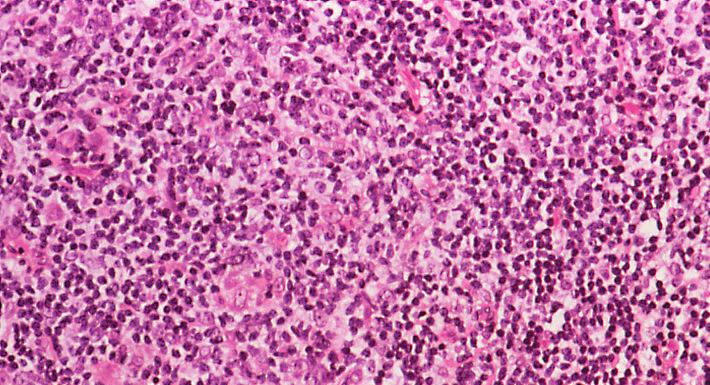
11808_kuxi_6288.jpg

人体微观防御体系的 “幕后英雄”
在人体微观的生理世界里,血液和淋巴系统宛如精密运转的 “超级工厂”,它们紧密协作,共同守护着生命的健康防线。然而,当这一复杂而有序的系统遭遇 “故障”,淋巴瘤 —— 这个隐匿在健康背后的 “阴影”,便可能悄然来袭。深入探究淋巴瘤,成为解锁人体健康密码、抵御疾病侵袭的关键所在。
生命洋流与免疫堡垒
人体的血液,如同身体内部奔腾不息的 “生命洋流”,在动脉与静脉构建的庞大 “血管网络” 中循环往复。血浆作为这股 “洋流” 的主体,承载着各类具有特殊使命的细胞。红细胞,恰似一艘艘装满 “氧气宝藏” 的 “运输船”,其内部富含的血红蛋白,赋予它强大的携氧能力。这些 “运输船” 从肺部出发,将氧气源源不断地输送到身体的每一个角落,返程时又将细胞代谢产生的 “废气”—— 二氧化碳带回肺部排出体外,维持着人体气体交换的动态平衡。血小板则像是一群训练有素的 “抢修队员”,一旦血管出现破损,它们迅速响应,聚集在伤口处,形成血栓,及时堵住 “缺口”,防止出血情况恶化。而白细胞中的淋巴细胞,更是免疫系统当之无愧的 “精锐部队”,在抵御病原体入侵、维持身体免疫稳态的战斗中发挥着核心作用。
淋巴系统作为人体免疫系统的重要组成部分,其 “防御据点” 遍布全身。扁桃体、胸腺、淋巴结、阑尾、骨髓以及脾脏等,宛如一座座坚固的 “免疫堡垒”,共同构成了淋巴系统的强大防线。骨髓,作为细胞的 “摇篮”,孕育出淋巴母细胞。这些淋巴母细胞如同具有无限潜力的 “种子”,在分化的道路上逐渐成长为不同类型的免疫细胞。
淋巴细胞的 “失控暴走”
在正常的生理秩序下,淋巴细胞遵循着严格的生长、分化和调控机制,有条不紊地执行着免疫防御任务,如同忠诚的 “卫士” 守护着人体的健康。然而,当淋巴细胞受到某些有害因素的影响,发生恶性转化时,就如同这些 “卫士” 突然失去控制,开始疯狂增殖,淋巴瘤便由此产生。淋巴系统犹如一张复杂而庞大的 “网络”,与血管系统相互交织、彼此关联。一旦淋巴细胞发生癌变,这些失控的肿瘤细胞就如同四处逃窜的 “破坏分子”,随着淋巴循环扩散到身体的各个部位,对人体的正常组织和器官造成严重破坏,严重威胁生命健康。
分类拼图的拆解与整合
淋巴瘤的分类极为复杂,宛如一幅庞大而精细的 “拼图”,需要专业的病理学家运用先进的显微镜技术,结合特殊的组织染色方法,对肿瘤组织切片进行细致入微的观察和分析,才能逐步拼凑出其完整的面貌。从宏观层面看,淋巴瘤主要分为霍奇金淋巴瘤和非霍奇金淋巴瘤两大类型。霍奇金淋巴瘤似乎对年轻男性群体有着特殊的 “偏好”,而非霍奇金淋巴瘤则在老年人群体中更为常见。
进一步深入细分,非霍奇金淋巴瘤又可依据细胞起源的不同,分为 B 细胞淋巴瘤、T 细胞淋巴瘤和 NK 细胞淋巴瘤,这与淋巴母细胞的分化轨迹密切相关。从临床角度出发,根据肿瘤细胞的生长速度、侵袭能力以及对人体的危害程度,淋巴瘤又被划分为侵袭性淋巴瘤和惰性淋巴瘤。
探秘发病根源与精准疗法
不同类型的淋巴瘤,其发病机制犹如隐藏在黑暗中的 “神秘密码”,背后涉及复杂的生物学过程和多种因素的相互作用。部分淋巴瘤的发生与基因突变密切相关,某些关键基因的突变会导致淋巴细胞的生长、分化和凋亡调控机制出现紊乱,使得细胞异常增殖,最终引发癌变。病毒感染也是诱发淋巴瘤的重要因素之一,例如 EB 病毒感染,它可能通过干扰淋巴细胞的正常生理功能,激活一系列异常的信号通路,从而增加患淋巴瘤的风险。此外,免疫系统功能的长期失调,如自身免疫性疾病患者由于免疫系统持续处于异常激活状态,也为淋巴瘤的发生创造了 “温床”。
针对这些复杂多样的发病机制,医学领域不断探索创新,为不同类型的淋巴瘤制定了个性化的精准治疗方案。化疗作为传统的治疗手段,通过使用化学药物,干扰肿瘤细胞的 DNA 合成、细胞分裂等关键过程,从而达到抑制肿瘤细胞生长和杀死肿瘤细胞的目的。放疗则利用高能射线的强大能量,对肿瘤部位进行局部照射,精确破坏肿瘤细胞的 DNA 结构,使其失去增殖能力。近年来,免疫治疗作为一种新兴的治疗方法,通过激活人体自身的免疫系统,增强免疫细胞对肿瘤细胞的识别和杀伤能力,为淋巴瘤的治疗开辟了新的途径。造血干细胞移植则适用于部分病情较为严重、常规治疗效果不佳的患者,通过重建患者的造血和免疫系统,彻底清除体内的肿瘤细胞,实现疾病的缓解和治愈。
预防与监测:健康的主动出击
淋巴瘤作为血液免疫系统的严重疾病,给患者及其家庭带来了沉重的负担和挑战。深入了解淋巴瘤的相关知识,对于早期发现、早期诊断和早期治疗至关重要。在日常生活中,保持健康的生活方式,如均衡饮食、适度运动、规律作息、避免过度劳累和长期接触有害物质,积极预防病毒感染等,都有助于降低患淋巴瘤的风险。同时,定期进行体检,关注身体的细微变化,若出现不明原因的淋巴结肿大、发热、盗汗、体重减轻等症状,应及时就医进行详细检查。